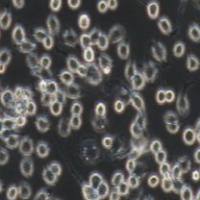
J774A.1 小鼠单核巨噬细胞

万千商家帮你免费找货
0 人在求购买到急需产品
- 详细信息
- 技术资料
- 英文名:
OCI-LY7
- 库存:
19
- 运输方式:
常温运输/干冰运输
- 年限:
详见说明书
- 生长状态:
贴壁/悬浮
细胞名称:人弥漫大B淋巴瘤细胞,OCI-LY7
细胞来源和细胞培养:详见说明书,说明书可来电直接获取
细胞冻存:低温冻存
1)简称: OCI-LY7
2)种属:人
3)来源:弥漫大B淋巴瘤;男性
4)污染:支原体、细菌、酵母和真菌检测为阴性
5)规格:T25瓶或者1mL冻存管包装
产品用途:仅用于科研实验,不做临床等其他用途!
人弥漫大B淋巴瘤细胞,OCI-LY7产品优势:
1)美国ATCC进口,为知名品牌,产品知名度高;
2)细胞为新批次生产,能保证研究所需的活性和灵敏度;
3)包装规格多样,能满足用户不同需求;
4)根据产品特性,采用干冰冻存,具体的运输方式,客户可与我销售部详细说明。
人弥漫大B淋巴瘤细胞,OCI-LY7在做生物细胞实验的过程中,需要用到细胞超声波破碎仪,以下是对超声波破碎仪的简单使用说明:
1.超声波细胞粉碎机严禁在变幅杆未插入液体内(空载)时开机,否则会损坏换能器或超声发生器。
2.对各种细胞破碎量的多少,时间长短,功率大小,有待用户根据各种不同细胞再摸索确定,选取值。此仪器输出功率较大,如选用Ф2、Ф3、或Ф6变幅杆时,应把功率调得小些,以免变幅杆过载而断裂。(Ф2 、Ф3<300W,Ф6<700W)
3.变幅杆选择开关是用来匹配不同规格的变幅杆与发生器的频率,阻抗的一致性。选择开关应打在对应的位置,当变幅杆磨损后可拨动开关至超声工作正常为止,此时档位与变幅杆规格不一定对应。
4.功率表显示的数值与电压、变幅杆插入液面深度及负载与被破碎样品的浓度、稠度有关,电压低于220V,变幅杆插入液面较深,负载浓度较大,显示数值可能要稍小,反之稍高(此数据为模拟参数,显示值的大小不影响超声波发射的实际功率)。
5.在超声破碎时,由于超声波在液体中起空化效应,使液体温度会很快升高,用户对各种样品的温度要多加注意。
6.超声波细胞粉碎机采用无工频变压器开关电源,在打开发生器机壳后切勿乱摸,以防触电。
以上说明仅供参考。
我司其他相关产品:
细胞来源和细胞培养:详见说明书,说明书可来电直接获取
细胞冻存:低温冻存
1)简称: OCI-LY7
2)种属:人
3)来源:弥漫大B淋巴瘤;男性
4)污染:支原体、细菌、酵母和真菌检测为阴性
5)规格:T25瓶或者1mL冻存管包装
产品用途:仅用于科研实验,不做临床等其他用途!
人弥漫大B淋巴瘤细胞,OCI-LY7产品优势:
1)美国ATCC进口,为知名品牌,产品知名度高;
2)细胞为新批次生产,能保证研究所需的活性和灵敏度;
3)包装规格多样,能满足用户不同需求;
4)根据产品特性,采用干冰冻存,具体的运输方式,客户可与我销售部详细说明。
人弥漫大B淋巴瘤细胞,OCI-LY7在做生物细胞实验的过程中,需要用到细胞超声波破碎仪,以下是对超声波破碎仪的简单使用说明:
1.超声波细胞粉碎机严禁在变幅杆未插入液体内(空载)时开机,否则会损坏换能器或超声发生器。
2.对各种细胞破碎量的多少,时间长短,功率大小,有待用户根据各种不同细胞再摸索确定,选取值。此仪器输出功率较大,如选用Ф2、Ф3、或Ф6变幅杆时,应把功率调得小些,以免变幅杆过载而断裂。(Ф2 、Ф3<300W,Ф6<700W)
3.变幅杆选择开关是用来匹配不同规格的变幅杆与发生器的频率,阻抗的一致性。选择开关应打在对应的位置,当变幅杆磨损后可拨动开关至超声工作正常为止,此时档位与变幅杆规格不一定对应。
4.功率表显示的数值与电压、变幅杆插入液面深度及负载与被破碎样品的浓度、稠度有关,电压低于220V,变幅杆插入液面较深,负载浓度较大,显示数值可能要稍小,反之稍高(此数据为模拟参数,显示值的大小不影响超声波发射的实际功率)。
5.在超声破碎时,由于超声波在液体中起空化效应,使液体温度会很快升高,用户对各种样品的温度要多加注意。
6.超声波细胞粉碎机采用无工频变压器开关电源,在打开发生器机壳后切勿乱摸,以防触电。
以上说明仅供参考。
我司其他相关产品:
| B淋巴细胞瘤细胞RAMOS(通过STR鉴定) |
| GLC-82人肺腺癌细胞 |
| THP 1单核细胞型淋巴瘤细胞(通过STR鉴定) |
| U-937淋巴瘤细胞 |
| NCI-H157人非小细胞肺腺癌细胞 |
| RPMI-8226多发骨髓瘤细胞(通过STR鉴定) |
| LIEP-P小细胞肺癌细胞 |
| SHG-44脑恶性胶质瘤细胞 |
| NCI-H209(人小细胞肺癌细胞)(通过STR鉴定) |
| U251神经胶质细胞瘤细胞(通过STR鉴定) |
风险提示:丁香通仅作为第三方平台,为商家信息发布提供平台空间。用户咨询产品时请注意保护个人信息及财产安全,合理判断,谨慎选购商品,商家和用户对交易行为负责。对于医疗器械类产品,请先查证核实企业经营资质和医疗器械产品注册证情况。
技术资料暂无技术资料 索取技术资料
人弥漫大B淋巴瘤细胞,OCI-LY7
询价